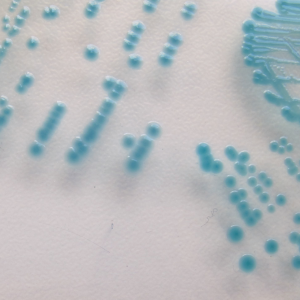
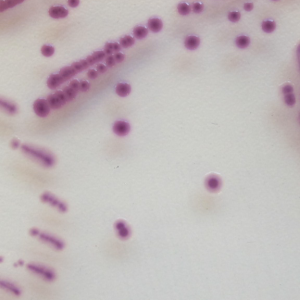

CÔNG TY TNHH KHOA HỌC KỸ THUẬT TOÀN CẦU

Trụ sở: Lầu 19, khu A, số 4 Nguyễn Đình Chiểu, Phường Đa Kao, Quận 1,
TP. Hồ Chí Minh, Việt Nam

Mã Số Thuế: 0304702378

Email nhận hoá đơn: hoadonnhap@global.net.vn

Hotline: 0908.090.555 / Email: dinh@global.net.vn

VP HCM: 48 Châu Thị Hóa, Phường 4, Quận 8, TP. Hồ Chí Minh

VP HN: Số nhà 59B, ngõ 148 Trần Duy Hưng, Phường Trung Hòa,
Quận Cầu Giấy, Hà Nội